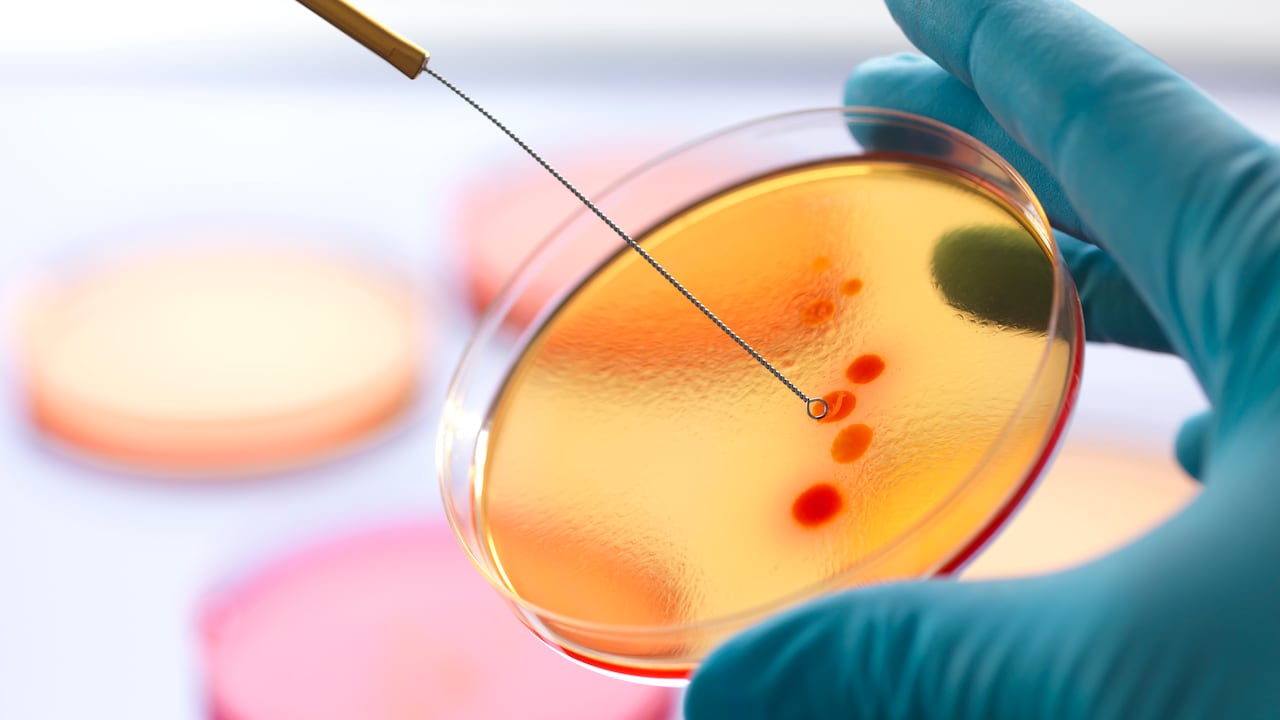

Mientras el coronavirus continúa dejando su estela de muerte en el mundo, cuya cifra de fallecidos se ubica en estos momentos en 3.451.720 y 166.244.011 contagiados, investigadores del Laboratorio de Virología y VIH del Instituto de Investigación del Hospital 12 de Octubre i+12, descubrieron un nuevo mecanismo de transmisión de la covid-19, aunque también ya encontraron la manera de combatirlo.

Los investigadores establecieron que el virus puede usar células inmunes del organismo para aumentar su posibilidad de infectar a otras células.
De acuerdo a lo publicado en la revista científica PLOS Pathogens, el SARS-CoV-2 posee unos mecanismos para entrar en la célula, permitir que sea infectada y favorecer así su multiplicación.
Sin embargo, en medio del estudio en el que participaron investigadores de Francia del Instituto de Biología Estructural de Grenoble, y de Italia, de Universita degli Studi di Milano, también señalaron la manera de combatir esta nueva forma de entrada y de propagación del coronavirus, puntualmente por medio de la utilización de moléculas denominadas glico-miméticas.
Sobre la manera descubierta de transmisión del coronavirus, los investigadores explicaron que las células cuentan con unos receptores, usados por los virus para adherirse y entrar mediante un arsenal de proteínas.
En cuanto al coronavirus, este cuenta con la glicoproteína S que se encuentra en la superficie y permite al virus entrar en las células al interactuar con el receptor ACE2.

Los científicos descubrieron que la proteína S también puede interactuar con otros receptores, que se encuentran en las células inmunitarias. Es decir, las células reconocen a la proteína S mediante los azúcares que poseen en su superficie y la dejan entrar.
Por lo tanto, dichos receptores cuando han logrado que el virus y la célula entren en contacto, tienen la capacidad de transmitir el virus a otras células, favoreciendo la multiplicación y mayor propagación del coronavirus.
De acuerdo con los investigadores, incluso podrían afectar a la respuesta inflamatoria pulmonar de algunos pacientes. Para combatir esta nueva forma de transmisión, los científicos señalan que se puede llevar a cabo por medio de los glico-miméticos, unas moléculas que se pueden disfrazar e imitar la apariencia de los azúcares.
En días pasados, Científicos de la Universidad de Texas A&M en Estados Unidos descubrieron la manera de neutralizar al coronavirus en menos de un segundo, según un artículo publicado en el portal Phys.org.
Los investigadores diseñaron un sistema experimental donde se demostró que la exposición del SARS-CoV-2 a altas temperaturas bastaría para neutralizar a la covid-19 en menos de un segundo.
Para ello, los científicos calentaron a casi 72 grados Celsius la sección de un tubo de acero inoxidable por medio del cual pasaba la solución que contenía el coronavirus.
De esa manera lograron establecer que el proceso térmico logra reducir la cantidad del virus en la solución en 100.000 veces, lo que según los investigadores bastaría para neutralizarlo y prevenir la transmisión del virus en un período significativamente más corto de lo que hasta ahora se creía posible, es decir, entre uno y veinte minutos.
“El potencial impacto es enorme (...) Tenía curiosidad por saber cuán altas son las temperaturas que podemos aplicar en un período de tiempo tan corto y ver si, de hecho, podíamos inactivar por calor el coronavirus en muy poco tiempo”, dijo al respecto Arum Han, profesor del Departamento de Ingeniería Eléctrica e informática de la Universidad de Texas A&M y coautor del estudio.

Tras dicho resultado, Arum Han considera que el método podría llegar a ser implementado en los sistemas de calefacción, ventilación y aire acondicionado existentes.
Ahora los científicos buscan construir un chip de prueba a escala de microfluidos, el cual les permita manejar con calor los virus durante períodos de tiempo mucho más cortos, con el fin de identificar una temperatura que permita dejarlos inactivo, incluso con un tiempo de exposición corto.